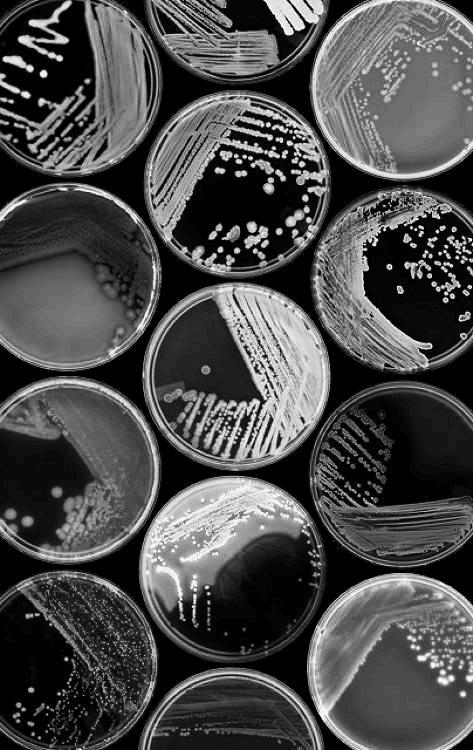
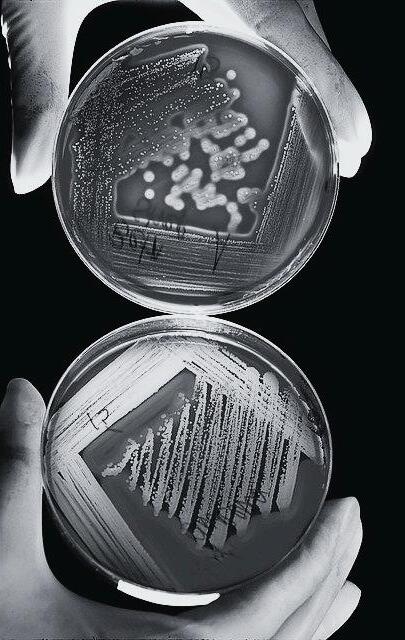
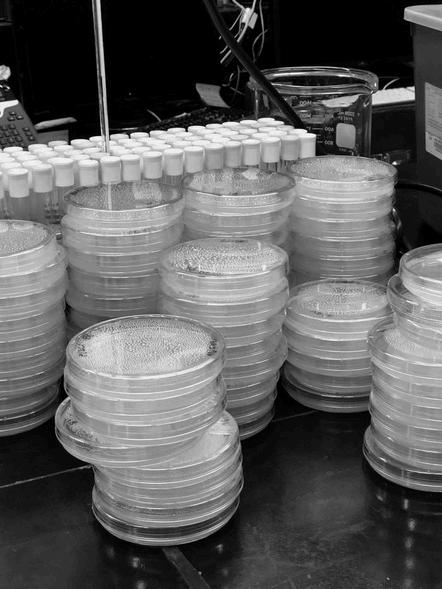
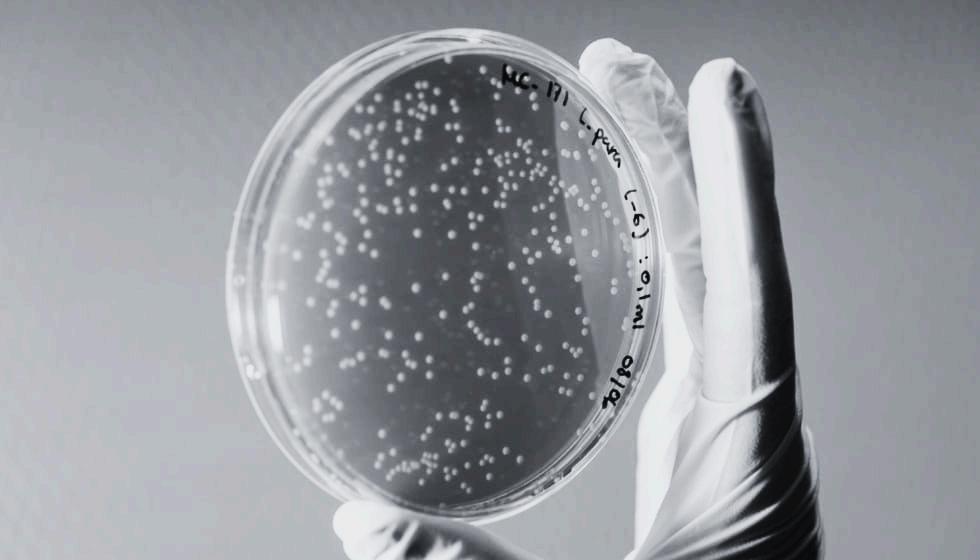

M I C R O B

![]()
M I C R O B
Editora en jefe
Cirenia Hernández Trejo
Directora Editorial
Itzel Villa Carmona
Directora de contenido
Fátima de Jesús López Sandoval
Dirección de arte
Tomás Guerrero
FátimadeJesúsLópez
Sandoval
Estudiante de la licenciatura en Química Clínica.
SherianKiramMárquez
Rodríguez
Estudiante de la licenciatura en Química Clínica.
ItzelVillaCarmona
Estudiante de las licenciaturas en Química Clínica y Pedagogía.
YetzabethHernándezMoreno
Estudiante de la licenciatura en Química Clínica.
1 1
Médicos & Odontologos, Virginia Cordero de Murillo Vidal, 91017 XalapaEnríquez, Ver.

Las bacterias se reproducen principalmente mediante fisión binaria, un proceso asexual rápido y altamente eficiente que permite que una sola célula dé origen a dos células genéticamente idénticas. Esta capacidad es clave para su éxito ecológico y su adaptación.
El proceso inicia con el crecimiento celular, donde la bacteria duplica su ADN mediante la replicación cromosómica. Una vez replicado, cada copia del ADN se ancla a regiones opuestas de la membrana. Después ocurre la iniciación del septo, donde proteínas como FtsZ forman un anillo contráctil que define el sitio de división. Finalmente, se completa la formación del tabique y la célula se separa en dos bacterias hijas idénticas.
Las bacterias pueden duplicarse en tiempos sorprendentemente cortos. En condiciones ideales, especies como Escherichia coli presentan tiempos de generación de apenas 20 minutos, mientras que otras pueden tardar horas. Factores como disponibilidad de nutrientes, temperatura, pH y presencia de antibióticos influyen directamente en la velocidad de reproducción.

4. IMPLICACIONES BIOLÓGICAS Y CLÍNICAS
La rapidez del crecimiento bacteriano explica por qué las infecciones pueden progresar velozmente y por qué el uso adecuado de antibióticos es crucial para evitar la selección de cepas resistentes. En el ámbito industrial, este mismo principio es aprovechado para producir biomasa, enzimas, probióticos y metabolitos de interés biotecnológico.
La reproducción bacteriana representa uno de los procesos biológicos más eficientes de la naturaleza, permitiendo la expansión, adaptación y persistencia de estos microorganismos en prácticamente cualquier ambiente.
Aunque la fisión binaria es el método principal, algunas bacterias muestran estrategias reproductivas alternativas:
Gemación, donde la nueva célula emerge como una pequeña yema; común en Hyphomicrobium
Fragmentación, presente en bacterias filamentosas, donde el filamento se rompe en células viables.
Esporulación, en géneros como Bacillus y Clostridium, no es un método reproductivo, pero permite sobrevivir condiciones extremas y reanudar la división cuando el ambiente mejora.
EL CRECIMIENTO BACTERIANO SE REFIERE AL AUMENTO EN EL NÚMERO DE CÉLULAS DENTRO DE UNA POBLACIÓN, MÁS QUE AL INCREMENTO DEL TAMAÑO INDIVIDUAL DE CADA BACTERIA.

ES UN CICLO CONTINUO REGULADO POR LA DISPONIBILIDAD DE NUTRIENTES, LA TEMPERATURA, EL PH Y OTROS FACTORES AMBIENTALES QUE DETERMINAN LA VELOCIDAD CON QUE OCURRE LA REPRODUCCIÓN MICROBIANA.
El crecimiento bacteriano ocurre siguiendo un patrón característico conocido como curva de crecimiento, que describe cómo cambia el tamaño de una población microbiana a lo largo del tiempo.
Esta curva se divide en cuatro fases principales, cada una con procesos fisiológicos y metabólicos específicos que determinan el comportamiento de las bacterias en un medio de cultivo.

En esta etapa inicial, las bacterias no se dividen de inmediato, ya que primero deben adaptarse al nuevo medio. Durante este periodo, se activan mecanismos para sintetizar enzimas, reparar estructuras celulares y recuperar energía. Aunque no hay incremento visible en el número de células, la actividad metabólica es muy intensa, preparando a la población para iniciar la división. La duración de la fase depende de factores como la edad del cultivo, la composición del medio y las condiciones ambientales.

Una vez adaptadas, las bacterias entran en un periodo de multiplicación acelerada, donde cada célula se divide a un ritmo constante mediante fisión binaria. En esta fase, la población aumenta de manera exponencial, duplicándose en intervalos regulares llamados tiempos de generación. Las bacterias están en su máxima actividad metabólica, producen enzimas de manera constante y muestran su mayor sensibilidad a antibióticos y agentes antimicrobianos. Esta etapa es especialmente importante en estudios de crecimiento, producción biotecnológica y evaluaciones de eficacia antimicrobiana.

A medida que los nutrientes del medio se agotan y se acumulan productos tóxicos del metabolismo, la velocidad de división celular disminuye. En esta fase, el número de bacterias que se dividen es igual al número de bacterias que mueren, por lo que la población se estabiliza Muchas especies activan mecanismos de supervivencia, como la producción de esporas o la síntesis de compuestos protectores. Esta fase constituye un equilibrio dinámico entre crecimiento y muerte, reflejando las limitaciones del medio.


4. FASE DE MUERTE O DECLIVE (DEATH PHASE)
Cuando los recursos se vuelven insuficientes y los desechos metabólicos resultan tóxicos, las bacterias ya no pueden mantener sus funciones vitales y comienza una disminución progresiva de la población. Las células mueren a un ritmo mayor que el de división, lo que provoca un descenso en la cantidad total de microorganismos. En esta fase, pueden detectarse células dañadas o viables pero no cultivables, lo cual es relevante en estudios de resistencia y supervivencia microbiana.


COMPRENDE LOS NUTRIENTES Y MECANISMOS QUE PERMITEN A LAS BACTERIAS OBTENER ENERGÍA, SINTETIZAR SUS COMPONENTES
CELULARES Y MULTIPLICARSE.
ESTOS DETERMINAN SU
CRECIMIENTO, METABOLISMO Y FACILIDAD DE CULTIVO.
Nutrientes esenciales
Macronutrientes
Carbono, nitrógeno, hidrógeno, oxígeno, fósforo y azufre, además de iones como K⁺, Mg²⁺, Ca²⁺ y Fe²⁺, indispensables para estructura celular, enzimas y reacciones energéticas.
Micronutrientes
Oligoelementos como Mn, Zn, Cu, Co y Mo, necesarios como cofactores enzimáticos.
Factores de crecimiento
Moléculas orgánicas que algunas bacterias no pueden sintetizar: vitaminas, aminoácidos y nucleótidos. Su presencia es crucial en bacterias exigentes como Haemophilus y Neisseria
Clasificación según su nutrición
Fuente de energía: fotótrofas (luz) y quimiótrofas (reacciones químicas).
Fuente de carbono: autótrofas (CO₂) y heterótrofas (compuestos orgánicos).
Las bacterias de importancia médica suelen ser quimioheterótrofas.
Transporte de nutrientes
Incluye difusión simple y facilitada, transporte activo y sistemas especializados como:
1.PTS: introduce y fosforila azúcares.
2.Sideróforos: captan hierro en ambientes pobres en este elemento.
3.Permeasas: transportan sustratos específicos.
Relación con medios de cultivo Las necesidades nutricionales determinan el tipo de medio:
1.Simples: sales + carbono (para bacterias poco exigentes).
2.Enriquecidos: sangre o extractos (bacterias exigentes).
3.Selectivos y diferenciales: útiles para aislar e identificar microorganismos.
LA DISPONIBILIDAD DE NUTRIENTES INFLUYE EN LA CAPACIDAD PATÓGENA, LA VELOCIDAD DE CRECIMIENTO Y LA FACILIDAD PARA AISLAR BACTERIAS. EL HIERRO ES UN NUTRIENTE CRÍTICO EN EL HUÉSPED, POR LO QUE MUCHOS PATÓGENOS PRODUCEN SIDERÓFOROS PARA OBTENERLO.